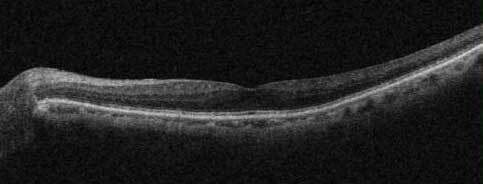
正常な黄斑の断層写真

黄斑上膜
視界の一部が歪んで見えたり、物がぼやけて見えることはありませんか?
これらの症状は黄斑上膜(網膜前膜)という目の病気が原因かもしれません。黄斑上膜は加齢とともに発症しやすくなる疾患で、適切な診断と治療により視機能の改善が期待できます。
宝塚市の仁川眼科医院では、複数の眼科専門医によるチーム医療体制で、黄斑上膜の精密な診断から手術治療まで一貫した治療を提供しています。
黄斑上膜とは
黄斑上膜は、網膜の中央部である黄斑の表面に薄い膜が形成される疾患です。

この膜は網膜前膜とも呼ばれ、まるでセロファンのような透明な膜が黄斑部を覆うように発生します。
黄斑は視力にとって最も重要な部分で、文字を読んだり、顔を認識したりする中心視力を司っています。黄斑以外ははっきりと見えているのでは無く、ぼーっと見えているだけで、文字を読んだりするような視力はありません。黄斑上膜が形成されると、この膜が収縮することで黄斑部の網膜にしわやゆがみが生じ、視機能に様々な影響を及ぼします。
正常な黄斑の断層写真

黄斑上膜ができ、黄斑にしわができた断層写真
黄斑上膜は50歳以上の方に多く見られ、年齢とともに発症率が高くなる傾向があります。片眼に発症することが多いものの、両眼に発症するケースも珍しくありません。症状の程度は個人差が大きく、軽度の場合は自覚症状がほとんどない方もいらっしゃいます。
黄斑上膜の症状
黄斑上膜の代表的な症状として、以下のような視覚症状が現れます。
- 変視症(物が歪んで見える)が最も特徴的な症状です。
直線が波打って見えたり、格子模様が歪んで見えたりします。アムスラーチャートという格子状の検査表を用いることで、ご自宅でも症状の程度を確認することができます。 - 中心暗点も重要な症状の一つです。
視野の中央部分が暗く見えたり、見たいものの中心部分が見えにくくなったりします。読書時に文字の一部が欠けて見える、人の顔の中央部分が見えないといった症状として現れることがあります。 - 視力低下は黄斑上膜の進行とともに生じます。
初期段階では軽度の視力低下にとどまりますが、網膜前膜の収縮が強くなると著明な視力低下を来すことがあります。 - 複視感(単眼複視)として、一つの物が二重に見えるような感覚が生じる場合もあります。
片目で見た時に二重に見える症状を訴える患者さんもいらっしゃいます。
黄斑上膜の原因
黄斑上膜の原因は、大きく特発性(原因不明)と続発性(他の疾患に伴うもの)に分類されます。
- 特発性黄斑上膜は大半を占めており、加齢に伴う自然な変化として発生すると考えられています。
加齢とともに硝子体が収縮・離脱する過程(後部硝子体剥離)で、硝子体皮質の一部が黄斑部に残存し、そこから細胞が増殖して網膜前膜を形成すると考えられています。
続発性黄斑上膜は、以下のような眼疾患に伴って発症します。
糖尿病網膜症、網膜剥離、網膜裂孔、ぶどう膜炎、眼外傷など
これらの疾患により網膜に炎症や損傷が生じると、創傷治癒過程で線維組織が増殖し、黄斑上膜が形成されます。
黄斑上膜の治療と検査
診断に必要となる検査
黄斑上膜の診断には、複数の精密検査を組み合わせた総合的な評価が必要です。
- 眼底検査
散瞳薬を用いて瞳孔を広げ、眼底カメラや眼底鏡を使用して黄斑部の状態を詳しく観察します。網膜前膜の存在や範囲、網膜の牽引の程度を確認することができます。
当院は広角眼底カメラを導入していますので、散瞳薬を使用せず広範囲の眼底を検査できます。 - 光干渉断層計(OCT)検査
網膜の断層像を高解像度で撮影することで、黄斑上膜の厚さや性状、網膜への影響を詳細に評価できます。当院では最新のOCT装置を導入し、より精密な診断を行っています。 - 蛍光眼底造影検査
造影剤を静脈内に注射して網膜の血管状態や循環動態を評価します。続発性黄斑上膜の原因となる疾患の有無を確認するために重要な検査です。 - 視野検査
中心視野の欠損や感度低下を客観的に測定します。黄斑上膜による機能的な影響を数値化することで、治療方針の決定に役立てています。 - アムスラーチャート検査
患者さんご自身でも行える簡便な検査です。格子模様を見て歪みの程度や範囲を評価し、病気の進行をモニタリングすることができます。
黄斑上膜の治療法
黄斑上膜の治療は、症状の程度や進行速度、患者さんの生活の質への影響を総合的に判断して決定します。
この病気は点眼や内服では改善せず、症状を改善するためには外科的治療(手術)が必要となります。しかし、黄斑上膜があれば必ずしもすぐに手術が必要というわけではありません。
当院では見え方や視力などに基づいて適切な判断を行い、必要であれば手術を行っています。
経過観察と外科治療が必要となる場合の違い
軽度の黄斑上膜で自覚症状が少ない場合は、OCT検査や視力検査による定期的な経過観察を行い、病状の変化を注意深くモニタリングします。この期間中、症状の悪化や視力低下がなければ、手術を急ぐ必要はありません。
一方、以下のような場合は外科的治療(硝子体手術)の適応となります。
- 視力が低下している場合
- 変視症が強く、日常生活に支障をきたしている場合
- OCT検査で網膜の著明な肥厚や構造異常を認める場合
- 症状が進行性に悪化している場合
手術の概要
黄斑上膜に対する手術は「硝子体手術」という方法で行います。
硝子体手術は非常に難しい手術で、日本眼科学会のHPでは「ガムをチィッシュペーパーからはがすようなイメージの、とても繊細で難しい手術に分類されます。」と表現 されています。
手術では、まず硝子体を除去し、その後黄斑上膜を慎重に除去します。網膜前膜の除去により、網膜の牽引が解除され、黄斑部の形態と機能の改善が期待できます。
高齢者では硝子体手術を行うと白内障が進行する事があるため、同時に白内障手術が行われる場合もあります。
手術後の見え方
網膜をけん引していた膜を取り除くことで、多くの場合視力が改善し、ゆがみの程度が軽減します。ただし、ゆがみが完全に無くならない事もあり、術前より視力が低下する場合もあります。
当院の手術について
当院では豊富な手術経験を持つ眼科専門医がチームで診察を行い、手術の執刀は兵庫医大の教授を務めた院長が執刀します。手術時間は通常30分から1時間程度で、日帰りの手術です。


